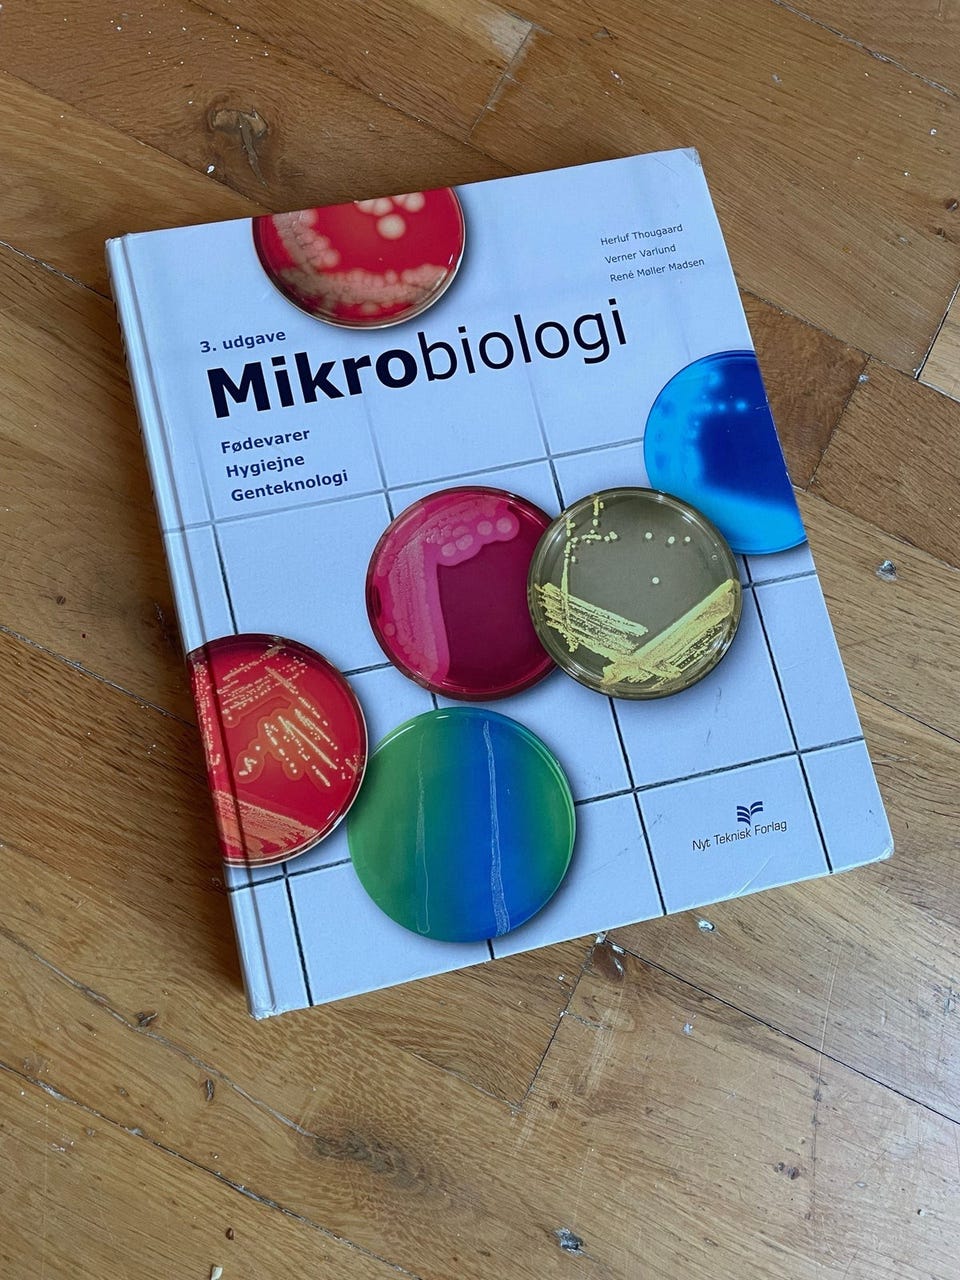
Galleribillede

Billedgalleri
Fødevarer, kemi, mikrobiologi
Til salg
Fragt fra 29,99 kr. + Tryg betaling 12 kr.
Tryg handel med Fiks færdig
Fiks færdig er DBA's nye betalings- og fragttjeneste. Efter levering har du 24 timer til at kontrollere varen, før pengene udbetales til sælgeren.
Varebeskrivelse
Stand: Brugt - men i god stand
Emne: Andre studiebøger
Fødevarer, kemi, mikrobiologi, bioteknologi, MF, emne: naturvidenskab, Øverst fra Venstre:
Videnskabs teori - for de biologiske fag af Hanne Andersen
99kr
SOLGT - Basis kemi C af Helge Mygind
99kr
Life - the science of Biology, volume 1, 11 udgave af sadava
199kr
Solgt - Mikrobiologi - fødevarer, hygiejne, genteknologi, 3 udgave af Herluf thougaard
75kr
Solgt- The good, the right and the fair af Mickey gjerris
75kr
Food analysis, 5 udgave af Suzanne Nielsen
299kr
Brugerprofil
Du skal være logget ind for at se brugerprofiler og sende beskeder.
Log indAnnoncens metadata
Sidst redigeret: 14.2.2025 kl. 20:47 ・ Annonce-ID: 482758